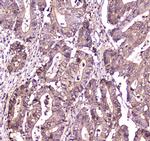
S100A10 Antibody in Immunohistochemistry (Paraffin) (IHC (P))

Search
Invitrogen
S100A10 Polyclonal Antibody
{{$productOrderCtrl.translations['antibody.pdp.commerceCard.promotion.promotions']}}
{{$productOrderCtrl.translations['antibody.pdp.commerceCard.promotion.viewpromo']}}
{{$productOrderCtrl.translations['antibody.pdp.commerceCard.promotion.promocode']}}: {{promo.promoCode}} {{promo.promoTitle}} {{promo.promoDescription}}. {{$productOrderCtrl.translations['antibody.pdp.commerceCard.promotion.learnmore']}}
图: 1 / 24
S100A10 Antibody (PA5-95505) in ICC/IF

Please note: We are reviewing Western blot images included in the antibody testing data in our catalog, including those provided by third parties. Unless expressly labeled or annotated as “raw-unedited”, Western blot images included in the antibody testing data in our catalog may have been edited, optimized or otherwise adjusted for presentation.
产品信息
PA5-95505
种属反应
已发表种属
宿主/亚型
分类
类型
抗原
偶联物
形式
浓度
规格
纯化类型
保存液
内含物
保存条件
运输条件
RRID
产品详细信息
Reconstitute with 0.2 mL of distilled water to yield a concentration of 500 µg/mL.
Positive Control - WB: human placenta tissue, human A431 whole cell, human Hacat whole cell, human U87 whole cell, monkey lung tissue, rat PC-12 whole cell, mouse NIH/3T3 whole cell. IHC: human breast tissue, human intestinal diffuse large B-cell lymphoma tissue, human liver cancer tissue, human lung adenocarcinoma tissue, human ovarian serous adenocarcinoma tissue, human tonsil tissue. ICC/IF: U2OS cell. Flow: A431 cell.|Store at -20°C for one year from date of receipt. After reconstitution, at 4°C for one month. It can also be aliquotted and stored frozen at -20°C for six months. Avoid repeated freeze-thaw cycles.
靶标信息
The S-100 family of calcium-activated proteins interact with a range of target proteins to modulate biological signaling pathways. Numerous cancer cell lines overexpress the plasminogen receptor S-100A10 on the extracellular cell surface, where it forms a heterotetrameric complex with Annexin II, though this association is not required for plasma membrane localization or binding and activation of plasminogen. Additionally, S-100A10 acts as a cellular chaperone for hepatitis B (Hep B) virus polymerase. Hep B virus polymerase normally localizes to the cytoplasm only, though in the presence of S-100A10 a portion relocates to the nucleus, implying a role for S-100A10 and intracellular calcium in the process of viral replication.
仅用于科研。不用于诊断过程。未经明确授权不得转售。
生物信息学
蛋白别名: Annexin II; annexin II ligand; calcium binding protein A11 (calgizzarin); Calpactin I light chain; Calpactin-1 light chain; Cellular ligand of annexin II; MGC111133; MGC133268; Nerve growth factor-induced protein 42C; OTTHUMP00000015270; P PRSS26; p10 protein; p11; p11 subunit; Protein S100 A10; Protein S100-A10; S-100 related protein, clone 42C; S100 calcium binding protein A10 (calgizzarin); S100 calcium-binding protein A10
基因别名: 42C; AA409961; AL024248; CAL12; Cal1l; CLP11; p10; p11; S100a10
UniProt ID: (Rat) P05943, (Mouse) P08207
Entrez Gene ID: (Rat) 81778, (Mouse) 20194




